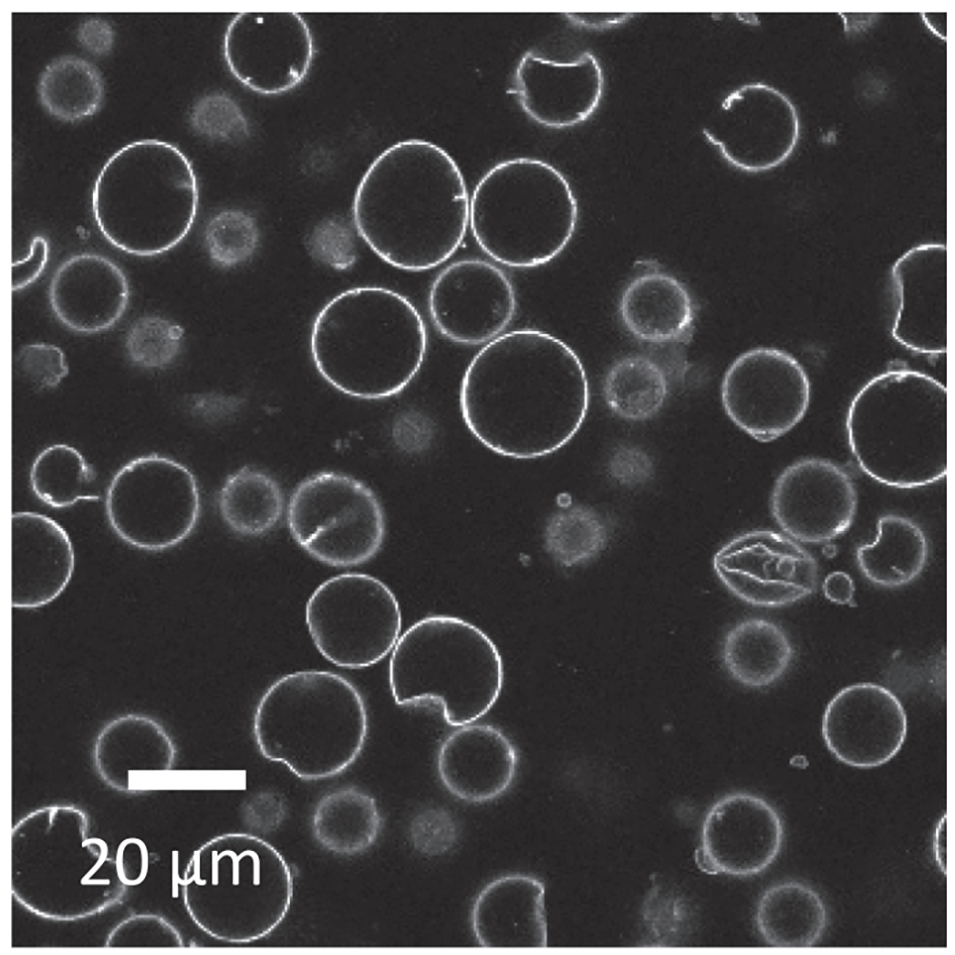

导读:
近期,有研究人员利用水包水(W/W)乳液中蛋白质微凝胶在界面处的自发交联,成功制备出稳定的蛋白质微胶囊。该微胶囊可通过调节分散相体积分数或蛋白质浓度调控尺寸,且在较宽pH范围和盐环境中保持稳定,十字花科蛋白微凝胶能直接自发交联形成微胶囊,乳清蛋白微凝胶则需添加少量阳离子油菜籽白蛋白辅助。相关研究以“Spontaneous formation of protein microcapsules using water-in-water emulsions stabilized by protein microgels”为题目,发表在期刊《Journal of Colloid and Interface Science》上。
本文要点:
1、本研究利用水包水(W/W)乳液体系,实现了油菜籽蛋白(十字花科蛋白,CMG)和乳清蛋白微凝胶(WMG)自发交联形成稳定微胶囊(MC)。
2、在聚环氧乙烷(PEO)/葡聚糖(DEX)乳液中,CMG可自发吸附于界面,经老化或80℃加热5分钟即发生交联,形成的MC悬浮液经稀释和洗涤后稳定。
3、MC尺寸(几微米至几十微米)可通过分散相体积分数(φ)或蛋白浓度调控,且在pH4-9及添加0.1M NaCl后仍稳定。
4、乳清蛋白微凝胶需添加微量阳离子油菜籽白蛋白(napin)以降低静电斥力,方可形成稳定MC。
5、该方法无需酶促交联,避免了油相去除步骤,为水溶性活性物质的包载提供了高效途径。
为何十字花科蛋白(CMG)能在界面自发交联,而乳清蛋白微凝胶(WMG)需油菜籽白蛋白(napin)辅助?
- 静电斥力差异:CMG在pH 4–7范围内表面电荷密度适中(等电点pH=6),界面密集堆积时静电斥力较弱,利于氢键/疏水作用主导的“冷凝胶化”自发发生。
- WMG的结构限制:乳清蛋白(主要含β-乳球蛋白)在pH 6.7带强负电(ζ电位≈-40 mV),高静电势垒阻碍微凝胶间交联。添加阳离子油菜籽白蛋白(等电点pH=9.5)后,通过电荷中和将ζ电位精准调控至-33~-38 mV,既抑制溶液中聚集,又允许界面交联发生。
本质上,蛋白界面行为受静电平衡支配,未来可设计“电荷开关型”嵌合蛋白,实现自适应性交联。
该方法形成的微胶囊如何突破传统载体的局限性?其分级稳定乳液的能力有何潜在价值?
- 突破油相依赖:传统O/W乳液法需后续除油(如溶剂挥发),易破坏活性成分;W/W乳液体系直接在水相中构建微胶囊,兼容亲水性物质(如多肽、核酸),且避免有机溶剂残留风险。
- 分级封装潜力:微胶囊本身可二次吸附于新乳液界面,形成“胶囊包裹液滴”的分级结构。这为设计时序释放系统提供可能——例如外层胶囊控释、内层液滴响应环境触发释放,实现药物/营养素的精准递送。
简言之,微胶囊的多级自组装特性为构建智能递送系统开辟了新路径,但需进一步研究其机械强度与渗透性调控机制。

图1.在pH7条件下含0.48wt%CMG的PEO-DEX乳液的共聚焦激光扫描显微镜(CLSM)图像。图像(a)为刚制备完成时拍摄,图像(b)为经80℃加热5分钟、稀释并静置使微胶囊沉降后拍摄。蛋白质已进行荧光标记。

图2.在pH4条件下含0.24wt%CMG的PEO-DEX乳液的CLSM图像。图像(a)为刚制备完成时拍摄,图像(b)为经80℃加热5分钟后拍摄,图像(c)为经4倍稀释并静置使微胶囊沉降后拍摄。蛋白质已进行荧光标记。

图3.在pH4条件下含0.24wt%天然十字花科蛋白的PEO-DEX乳液的CLSM图像。图像(a)为加热前拍摄,图像(b)为经80℃加热、稀释并静置使微胶囊沉降后形成的微胶囊图像。蛋白质已进行荧光标记。

图4.葡聚糖(DEX)相体积分数为10%的DEX-PEO乳液的CLSM图像,该乳液在pH4条件下形成,含1.1wt%微凝胶。图像(a)为加热前拍摄,图像(b)为经80℃加热5分钟、稀释并静置使微胶囊沉降后拍摄。蛋白质已进行荧光标记。

图5.在不同条件下,含CMG的PEO-DEX乳液中形成的微胶囊的CLSM图像:(a)分散相体积分数φ=10%、CMG浓度C=0.24wt%;(b)φ=10%、C=1.1wt%;(c)φ=25%、C=0.24wt%;(d)φ=25%、C=1.1wt%。图像均为稀释并静置使微胶囊沉降后拍摄。为清晰展示,图5b和图5d中插入了5倍放大的特写图像。蛋白质已进行荧光标记。
图6.在pH4、分散相体积分数φ=10%条件下,含0.15wt%油菜籽蛋白分离物(RPI)微凝胶的PEO-DEX乳液的CLSM图像。经80℃加热5分钟、稀释并静置使微胶囊沉降后的图像。蛋白质已进行荧光标记。

图7.在pH6.7条件下,浓度为0.01wt%的乳清蛋白微凝胶(WMG)的zeta电位随添加的油菜籽白蛋白(napin)质量分数(F)的变化曲线。误差棒代表每个样品经三次zeta电位测量后的标准偏差。

图8.在分散相体积分数φ=10%、pH6.7条件下,含0.3wt%WMG及不同质量分数油菜籽白蛋白(napin)的PEO-DEX乳液经75℃加热5分钟后形成的微胶囊的CLSM图像。图像为稀释并静置使微胶囊沉降后拍摄。蛋白质已进行荧光标记。图中标注了不同的napin质量分数。

图9.分散相体积分数φ=25%、含0.3wt%WMG和0.02wt%油菜籽白蛋白的PEO-DEX新鲜乳液的CLSM图像(134×134µm):(a)刚制备完成时;(b)经75℃加热5分钟并稀释后;(c)稀释样品经涡旋混合并静置使微胶囊沉降后。蛋白质已进行荧光标记。

图10.由十字花科蛋白微凝胶(CMG)微胶囊稳定的PEO-DEX乳液的CLSM图像(对应图4b中的微胶囊)。蛋白质已进行荧光标记。插图为主图像左下角液滴的特写。
论文链接:https://doi.org/10.1016/j.jcis.2025.138109






